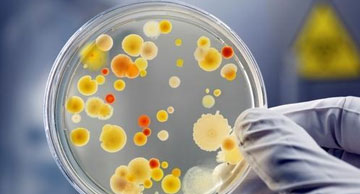

About MPTRI
Microbiology Testing Labaratory
Founded in 2007, MPTRI has built a reputation for having a staff of some of the industry most experienced and competent professionals.
MPTRI stays in touch with the latest processes, techniques and technologies so you can be offered the most current, up to date laboratory services.
Our Laboratory is a team of experienced professionals specializing in several standard tests including IS, APHA, AOAC, ASTM, IP, BP, USP etc;
MPTRI participates in the National Accreditation Board of Testing Laboratory and Inter Laboratory Proficiency Testing Programme.
We are pleased to announce that MPTRI now offers overnight sampling for our laboratory customers (conditions apply) please call for details.

Our Services
Microbiology Testing Labaratory
Food & Agriculture
Food analysis is the discipline dealing with the development, application and study of analytical procedures for characterizing the properties...
Read MoreWater Testing
Water-borne illnesses being one of the major preventable calamities often contaminated with organic and inorganic impurities like; high levels...
Read MoreMicrobiology Testing
Microbiology testing services are a crucial requirement across many industries worldwide where products, processes and human health are at risk...
Read MoreEnvironmental Monitoring
The Company has complete facility to execute various jobs related to environmental services MPTRIprovides full service environmental...
Read MoreTraining & Consultancy Services Inspection
Trainings – HACCP, GMP, Food Safety, Sanitization, and Analytical instruments etc. We conduct different training programmes specifically designed to ...
Read MoreShelf life studies & Nutritional Labeling
Shelf life, in specific storage conditions, means the maximum period of time in which the passing of single reactive events cause modificatioons...
Read More